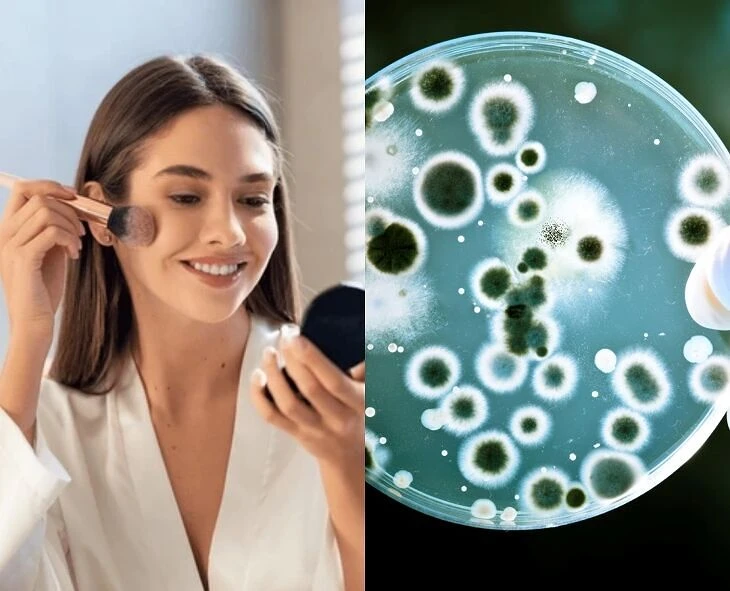

-
Cesarean deliveries have become common these days. Experts say that some precautions should be ta...
-
Some people suffer from cracked feet regardless of the season. Experts say that these can be chec...
-
-
In today's society, a family runs smoothly only when both husband and wife work. In this context,....
-
-
-
-
-
Food plays a key role in the growth of children. Experts suggest that children should be graduall....
-
-
A woman needs more calories in her life during the breastfeeding stage. Experts say that breastfe...
-
It is known that honey has many health benefits. However, experts say that honey plays a key role...
-
Stay Connected
Email: npnlivecontact@gmail.com
Phone: +91 9652529542
Get Newsletter
Subscribe to our newsletter to get latest news, popular news and exclusive updates.
Featured News
Advertisement dgvzvzdv
-
Thyroid, PCOS, and diabetes can cause dry skin and hair. Dermatologists recommend using shampoos that are less concentrated to prevent this. "Choos...
-
-
Some women leave their makeup brushes uncleaned after applying makeup. They use them after a few days. This is very dangerous, a study has revealed...
-
-
Steaming your face cleanses your skin from within. Experts say that it improves blood circulation and makes your skin glow. Before doing a steam fa...
-
Long established fact that a reader will be distracted
- by Ninurta
- 16 April 2017
-
Long established fact that a reader will be distracted
- by Ninurta
- 16 April 2017
-
Long established fact that a reader will be distracted
- by Ninurta
- 16 April 2017